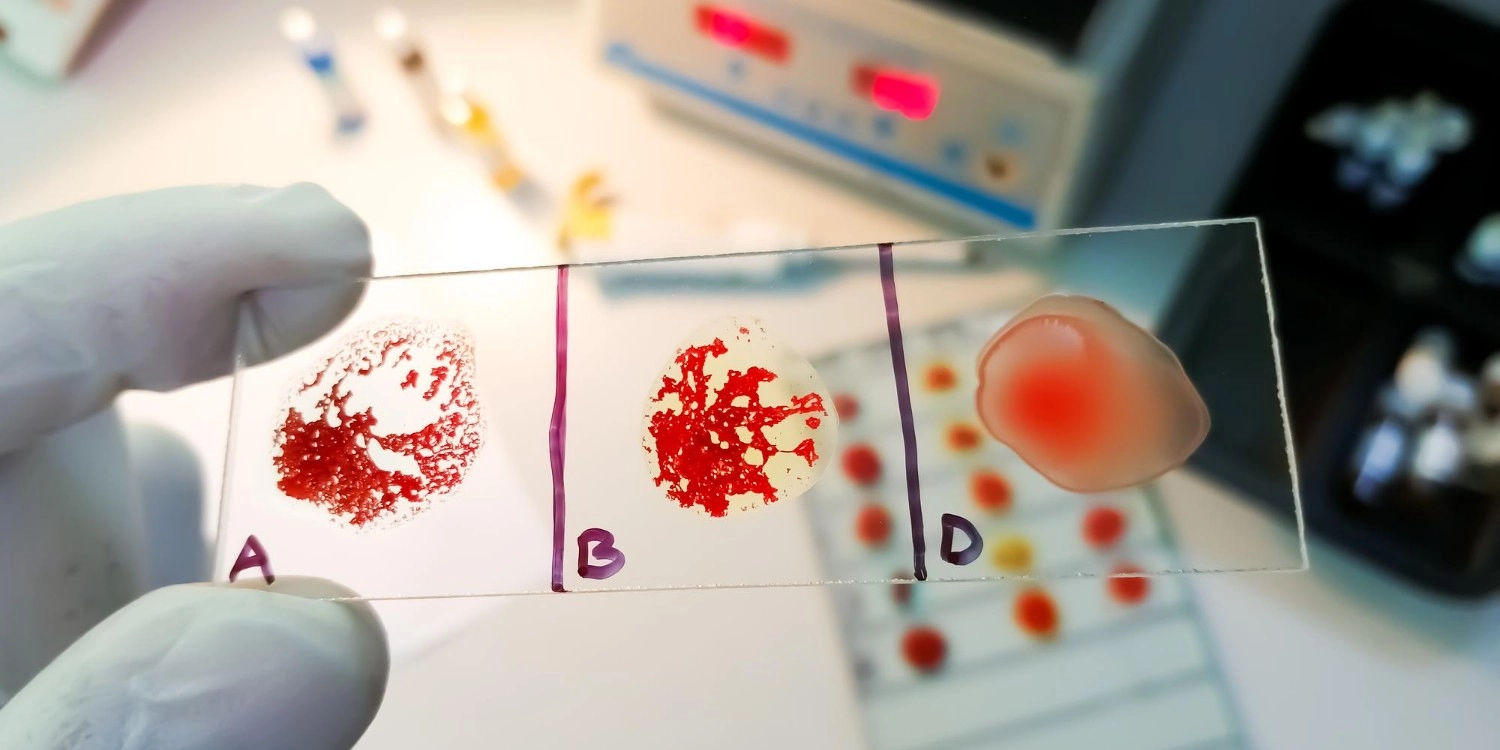
Laboratorio Perez Elizalde - Servicios - Endocrinologia (3)
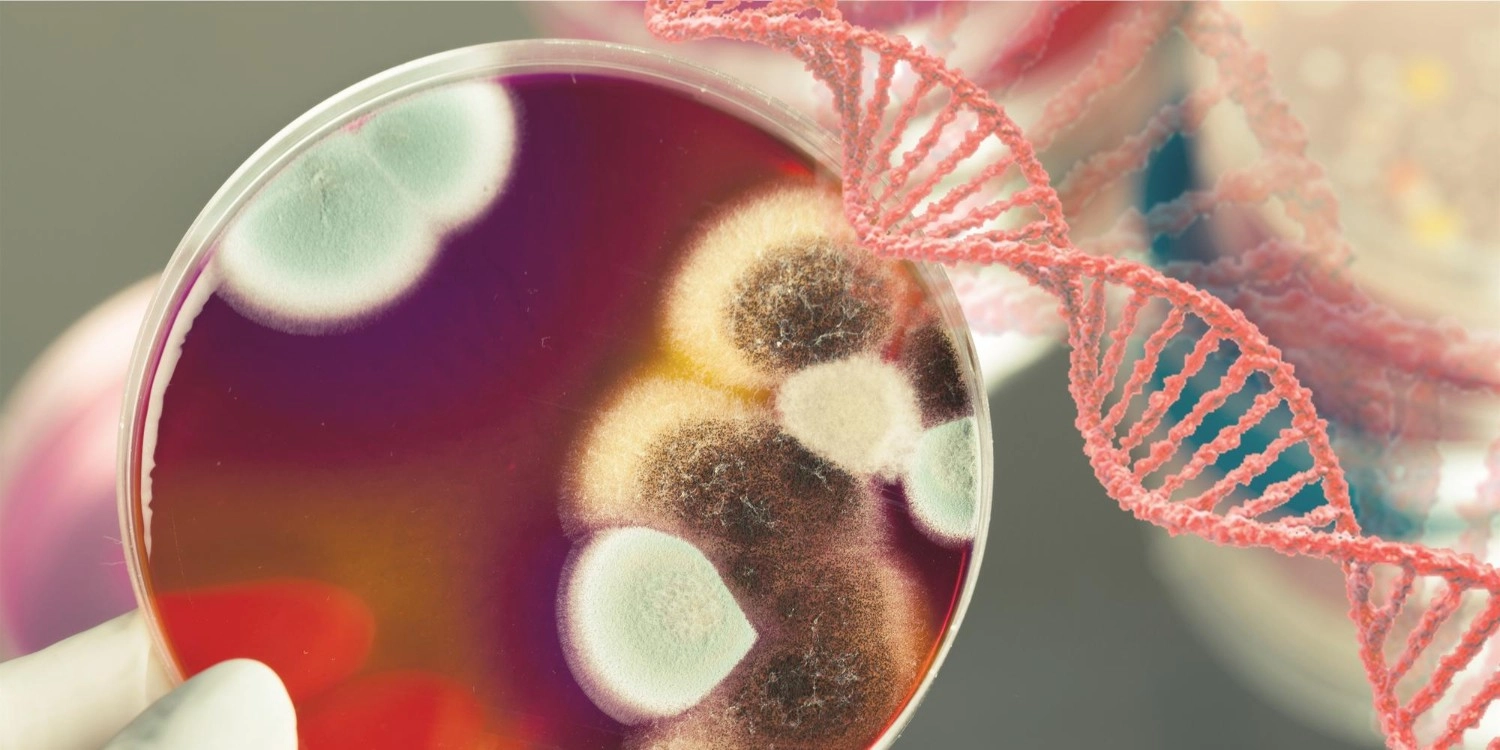
Laboratorio Perez Elizalde - Servicios - Endocrinologia (4)
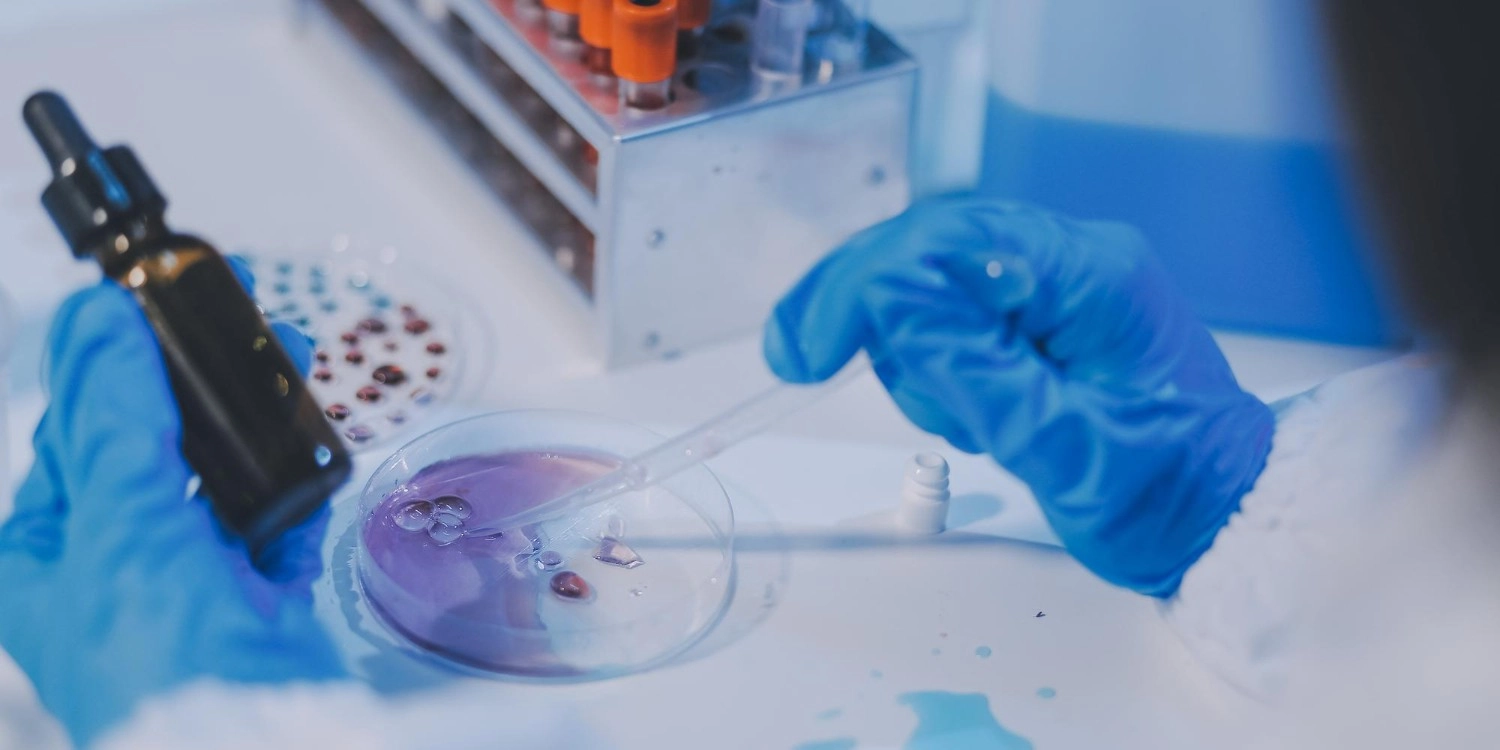
Laboratorio Perez Elizalde - Servicios - Inmunologia (1)
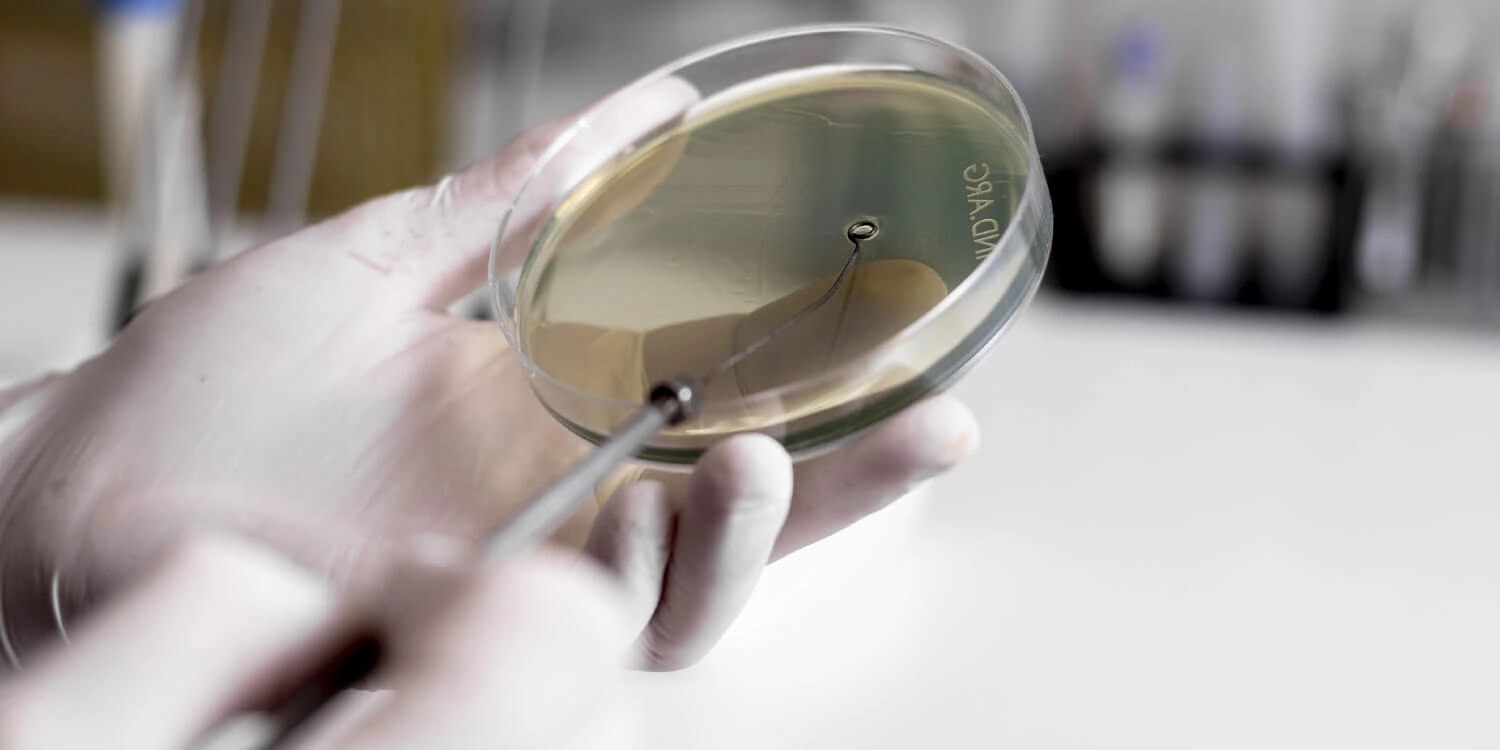
Laboratorio Perez Elizalde - Servicios - Autoinmunidad (1)
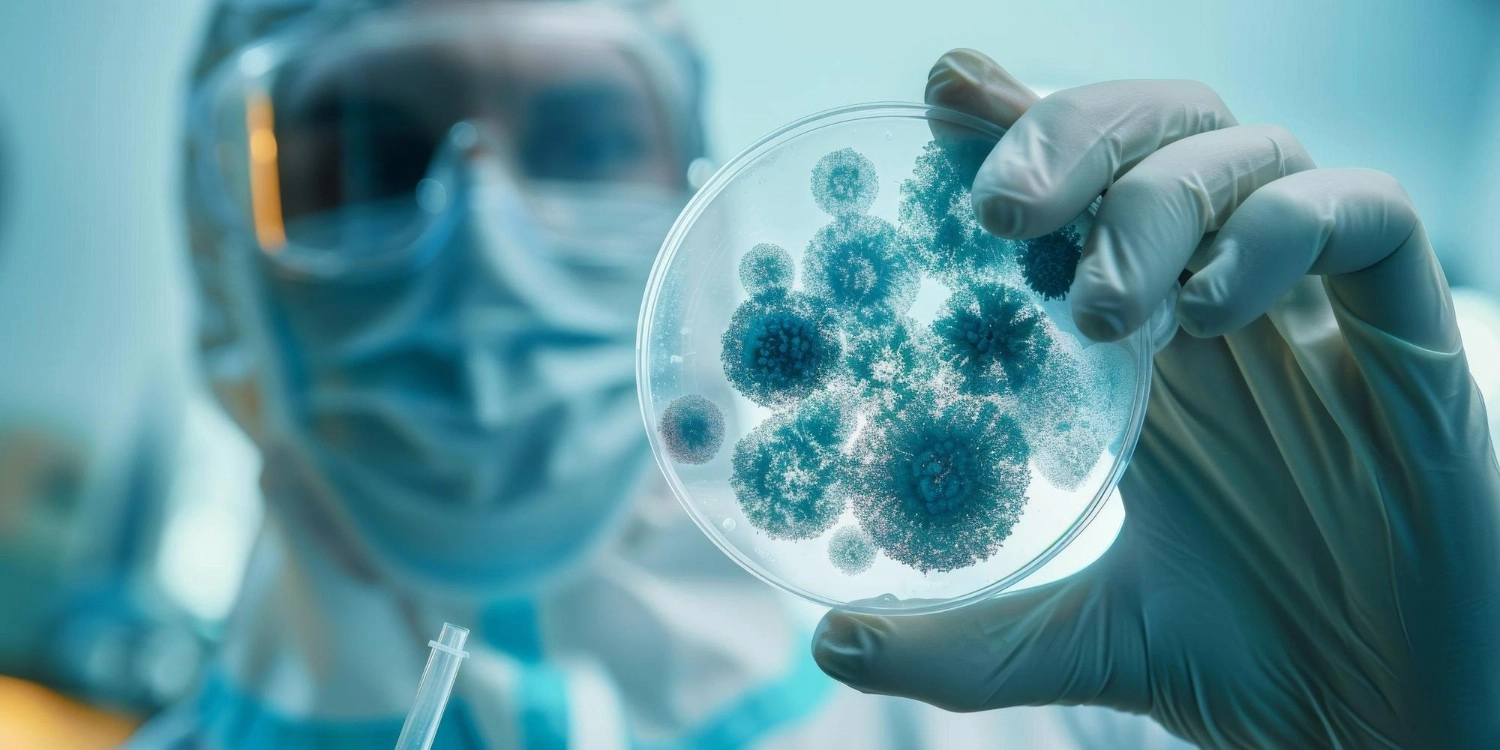
Laboratorio Perez Elizalde - Servicios - Virologia (2)
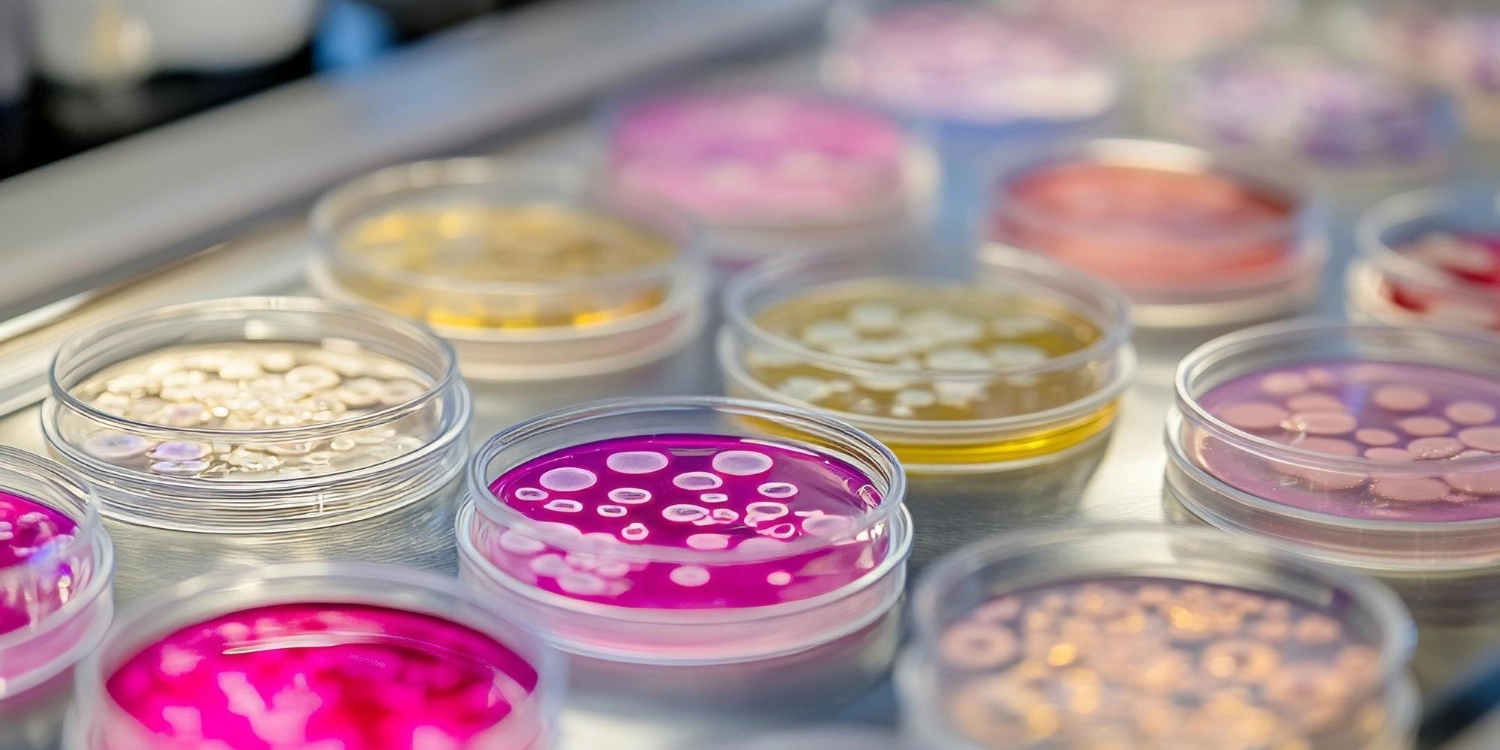
Laboratorio Perez Elizalde - Servicios - Microbiologia (3)
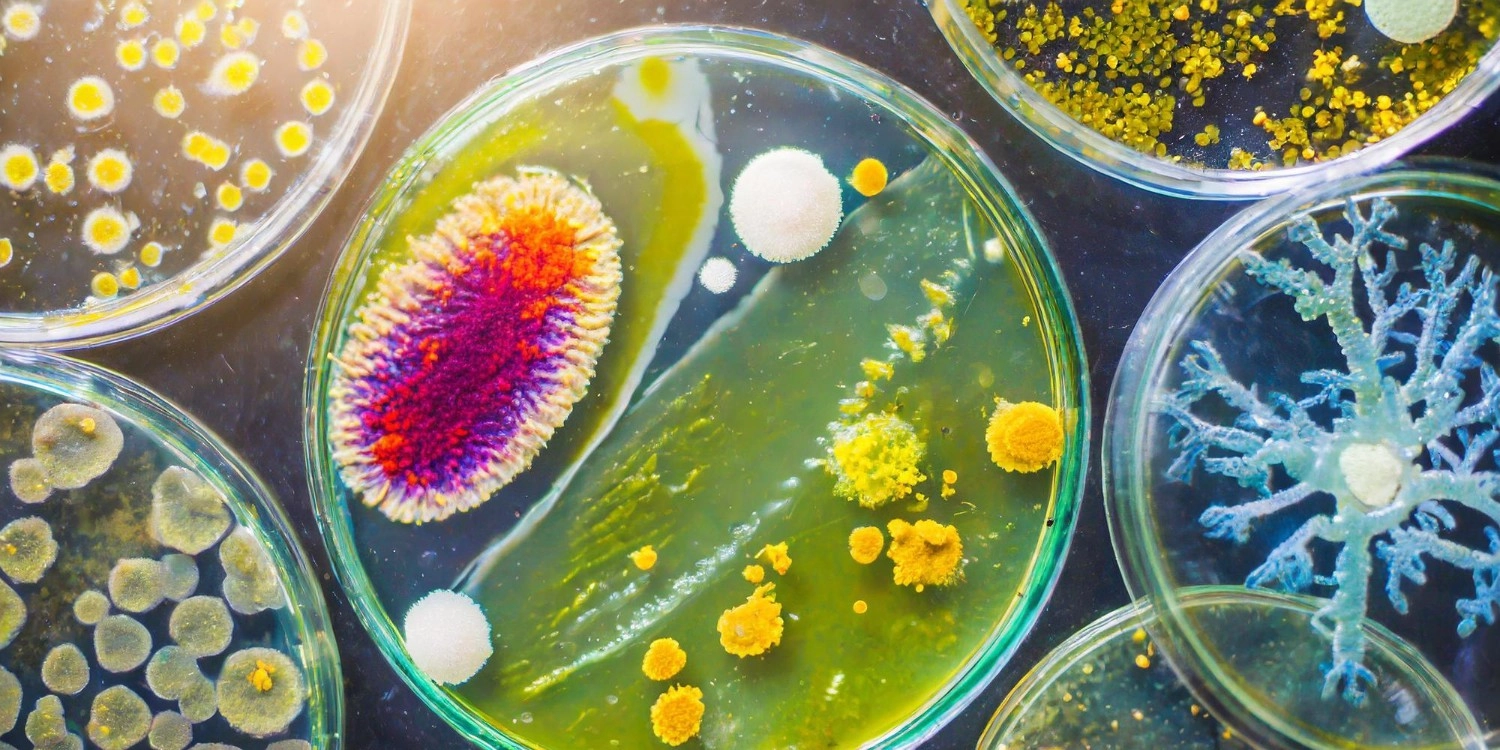
Laboratorio Perez Elizalde - Servicios - Microbiologia (4)

Servicios de Diagnóstico: Resultados confiables con la agilidad que su salud necesita
Los estudios que te aseguran confianza
Tabla de contenidos
Hematología
Estudia las células de la sangre y sus precursores, glóbulos rojos, blancos y plaquetas, así como los trastornos estructurales y bioquímicos de estos elementos que puedan conducir a una enfermedad. Las plaquetas son necesarias para que la sangre se coagule. Los glóbulos rojos transportan el oxígeno de los pulmones a los tejidos y retiran el dióxido de carbono. Los glóbulos blancos ayudan a combatir las infecciones.




Uroanálisis
Un examen general de orina constituye uno de los métodos más comunes de diagnóstico médico. Un examen completo consta de varias determinaciones: macroscópico, físico-químico, microscópico. Ayuda a detectar enfermedades renales, infecciones urinarias e incluso diabetes.




Química clínica
Es la especialidad que estudia los aspectos químicos de la vida humana en la salud, y de la aplicación de los métodos químicos y bioquímicos de laboratorio al diagnóstico, control del tratamiento, seguimiento, prevención e investigación de la enfermedad. Los análisis más comunes son glucemia, uremia, acido úrico, colesterol y triglicéridos.



Medio interno
Es un concepto definido para indicar el medio hidrosalino de un organismo, con sus propiedades fisico-químicas correspondientes, se determina sodio, potasio, Magnesio y Calcio.




Endocrinología
Es una disciplina de la medicina que estudia el sistema endocrino y las enfermedades provocadas por un funcionamiento inadecuado del mismo. Algunas de estas enfermedades son diabetes mellitus provocada por deficiencia de insulina o resistencia a su acción, hipotiroidismo por déficit en la producción de hormonas tiroideas, hipertiroidismo por excesiva producción de hormonas tiroideas y enfermedad de Cushing.

Inmunología
Es el estudio que permite comprobar la presencia de anticuerpos en la sangre. Se basa en un examen serológico que busca conocer la exposición o presencia previa de un microorganismo patógeno en particular y a partir de ella la capacidad de respuesta del individuo a tal infección. Se estudian anticuerpos contra chagas, rubeola, Toxoplasmosis, HIV, etc.

Autoinmunidad
Una enfermedad autoinmune está causada por el sistema inmunitario, que ataca las células del propio organismo. El sistema se convierte en el agresor y ataca y destruye a los propios órganos y tejidos corporales sanos, en vez de protegerlos. Algunas enfermedades autoinmunes son diabetes tipo 1, artritis reumatoide, lupus eritematoso sistémico, esclerosis múltiple y enfermedad celíaca.

Virología
Estudia los virus, su material genético (ADN o ARN). Se centra en aspectos tales como estructura, clasificación y evolución, mecanismos de infección. Se estudian virus como los de la hepatitis, citomegalovirus, Epstein Baar, COVID, Dengue, entre otros.

Microbiología
Es una ciencia parte de la microbiología que estudia e investiga las características morfológicas y biológicas de las bacterias. Se realizan cultivos de orina, exudados faríngeo, uretral y vaginal.

Monitoreo de Drogas de Abuso y Terapéuticas
Constituyen las utilizadas con fines médicos o terapéuticos que ayudan a controlar o calmar dolencias provocadas por enfermedades, y producen cambios en el estado mental y físico de la persona. Se dividen en dos tipos: depresoras y estimulantes del sistema nervioso central. Por ejemplo, anticonvulsivantes, etc.




Toxicología laboral
Estudia los productos químicos tóxicos usados en la industria y trata su identificación, análisis, mecanismo de acción, metabolismo, interacción, tratamiento y prevención. Su fin es la prevención de lesiones tóxicas y sus consiguientes alteraciones de la salud. Se estudia la exposición a sustancias como arsénico, mercurio, plomo o derivados del petróleo.





